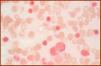

Myelodysplastic/myeloproliferative neoplasia with ring sideroblasts and thrombocythemia (MDS/MPN-RS-T) is a new and well characterized entity in the 5th edition of the WHO Classification of Hematopoietic and Lymphoid Tissues.1
With the advent of next generation sequencing, genetic studies showed that SF3B1, a spliceosome gene, was frequently mutated in ring sideroblasts (RS) cases (>80%) and provided support to the distinction of this entity, replacing the former provisional refractory anemia with RS and thrombocytosis (RARS-T).2,3
The MDS/MPN-RS-T is rare, <3% of myelodysplastic syndromes (MDS), but should always be investigated in the presence of thrombocytosis since it presents peculiar characteristics, as compared to MDS-RS and essential thrombocythemia (ET), such as: variable outcomes (76m, 63m and 117m, respectively); thrombotic events more frequent than in MDS-RS, but less than in ET, and; a lower rate of transformation into acute myeloid leukemia than ET.4
The MDS/MPN-RS-T overlaps myelodysplastic and myeloproliferative features, namely RS and thrombocytosis, associated with abnormal large megakaryocytes similar to those seen in MPN–BCR-ABL1 negative.1
Usually the patients are elderly females, with a median age higher than that of the ET patients (74 years versus 50–60, respectively).1 Symptoms vary from none to fatigue, bleeding and weight loss.5 Splenomegaly may be palpable in 1/3 of the cases.
Peripheral blood findings include macrocytic or normocytic anemia, anisopoikilocytosis, myeloid left shift and mild dysplastic features. Bone marrow biopsy corroborates the hypercellular marrow with atypical megakaryocyte hyperplasia seen in smears. Marrow G-banding karyotypes are generally normal, but patients usually present the SF3B1 mutation (predictive value for disease phenotype with RS),6 concurrent with a myeloproliferative driver mutation, such as JAK2V617F (∼50%), CARL(<3%) or MPL (<3%). Additional mutations observed are: TET2 (25%), ASXL1 (20%), DNMT3A (15%) and SETBP1 (10%).3
The diagnostic criteria are: the presence of anemia with erythroid dysplasia with or without multiple lineage dysplasia, >15% of RS, <1% of blasts in the peripheral blood, and <5% in the bone marrow, persistent thrombocytosis with platelets ≥450.000μL, the SF3B1 mutation (or in its absence, no recent use of cytotoxic or growth factor therapy); none of the following rearrangements: BCR-ABL1; PDFGRA, PDFGRB, FGFR1, PMC1-JAK2, t(3;3)(q21.3;q26.2), inv(3)(q21.3q26.2), del(5q), and; no history of myeloproliferative neoplasm, myelodysplastic syndrome (except MDS-RS), or other MDS/MPN.1
From the clinical point of view at diagnosis, many cases seem like ET with a trend to an enlarged mean corpuscular volume (MCV) and near normal hemoglobin values. The guiding principle for the diagnosis is the iron staining by Prussian blue (Perl's reaction). Should this test not be performed, the cases would remain misdiagnosed as ET.
The RSs are erythroid precursors containing iron-loaded mitochondria (ferritin) surrounding more then 1/3 of the nucleus (Figure 1). In addition to the clonal conditions associated with the RS, such as MDS, ET and primary myelofibrosis, the RS may appear due to exposure to alcohol, some drugs (isoniazid, chloramphenicol, linezolid and penicillamine), lead and zinc intoxication, copper or pyridoxine deficiency, and as inherited conditions, some X-linked. However, regardless of the cause, RS identifies ineffective erythropoiesis and mitochondrial iron overload. The mitochondrial ferritin is not detectable in normal erythropoiesis. The molecular pathogenesis is that the SFB3B1 mutation could alter the ABCB7 gene expression dysregulating mitochondrial iron homeostasis, consequently forming the ring sideroblasts.6,7
The SF3B1 (splicing factor 3B subunit 1) gene is located on the chromosome 2q33.1, is involved in the spliceosome, being K700E the most frequent (>50%) mutation. When the SF3B1mut is detected, the RARS with reacting thrombocytosis is ruled out. The SF3B1mutation dysregulates mitochondrial iron homeostasis, resulting in the formation of the RS. It is thought that the SF3B1 haploinsufficiency correlates with the development of the RS, supported by the fact that its pharmacological inhibitor, meayamycin, induces the RS in healthy in vitro BM cells of sf3b1-heterozygous-knock-out mice.6
Considering the predictors of survival, Patnaik et al. (2016),7 developed a prognostic model based on the mutational profile (Table 1).
Predictors of survival.7
| Score | ||||
|---|---|---|---|---|
| Criteria | Points | Risk categories | Sum of points | Median survival |
| Abnormal karyotype | 2 | Low | 0 | 80m |
| ASXL1mut and/or SETBP1mut | 1 | Intermediate | 1 | 42m |
| Hb<10g/dL | 1 | High | 2 | 11m |
As for therapy, the MDS/MPN-RS-T patients are frequently treated with erythropoiesis stimulating agents (if the serum levels of EPO are <500mU/mL) or transfusions for anemia; antiplatelet agents (ex. low dose aspirine) for reduction of the risk for arterial thrombosis, and; cytoreductive therapy (ex. Hydroxyurea, Interferon) for those cases with increased risk for thrombosis.4,5,7
In the case of marked thrombocytosis (≥1000×109/L), or any evidence of bleeding, an investigation for acquired von Willebrand's disease (VW) should be conducted (antigen, ristocetin cofactor activity and VW's multimeric pattern) before starting aspirin. Treatment of the underlying medical condition may result in remission, but more than one therapeutic approach is often necessary to treat acute bleeding and prophylaxis during invasive procedures and include desmopressin, VWF-containing concentrates, intravenous immunoglobulin, plasmapheresis, or recombinant factor VIIa.8
In summary, the precise diagnostic work-up associated with the mutational profile is important to distinguish this entity from the ET and MDS-RS.
Conflicts of interestThe authors declare no conflicts of interest.